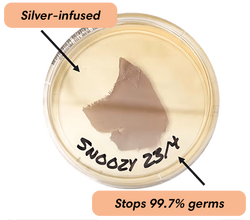
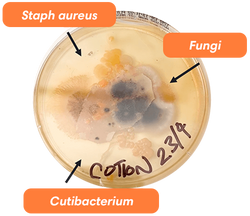

100,000+ happy customers have spoken
based 5,814 Reviews
"This silver-infused pillowcase changed our hair and skin forever"

"In as little as four weeks, the pillowcase works to prevent breakouts"

"An amazing addition to beds everywhere to help promote the well-being of your skin"


Make Skincare Effortless
No 10-step routines, no extra serums, creams, or lotions. We're committed to creating products that fit seamlessly into your life - helping your skin be at its natural best.
Shop our best sellers
12 iterations later, we've created the perfect pillowcase - from fit to functionality - and new products to supplement your beauty sleep.
-
Infused with silver
Silver's been used for years as a natural, safe way to stop bacterial spread.
-
Stops bad bacteria
We're talking P. Acnes and Staph, shown to trigger acne and other skin concerns.
-
Lab-tested
Antibacterial for over two years, you can sleep easy knowing your silver's working.
Repels Bacteria
Like An Invisible Forcefield
Our pillowcases can have 1000x more bacteria than your toilet seat, shown to clog pores and trigger breakouts. Like an invisible forcefield, Snoozy's silver stops 99.7% of the nasties before they affect your skin
SNOOZY
COTTON
*7 day growth comparison after sleeping on Snoozy and cotton for 3 nights without washing
Snoozy In The Wild
Made For Everyone
-
All Skin Types
-
Affordable
-
Vegan Options
-
Ultra Soft
-
Easy Care
-
Top Rated














